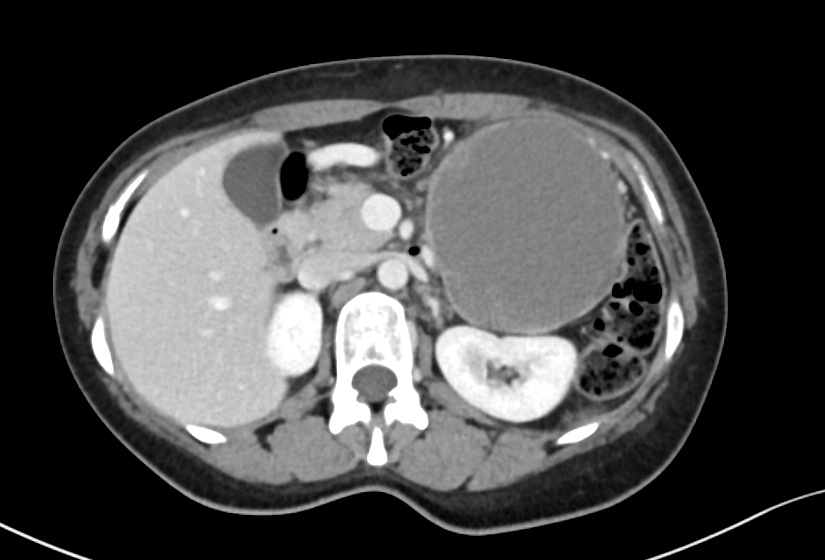
Dr Ihab Suliman tweet media

Le Nhat Khoa
265 posts


Le Nhat Khoa
@thisisnorvas
2/6 medical student @ctump1979 | Class of '28. | All contents posted in here is for education and entertainment. Not medical advice.


Bản đồ sao của Binance, lý do out bớt $BNB Xét về cơ bản: Tiêu chuẩn để list coin trên #Binance thời gian gần đây dường như chỉ cần có tiền là được. List nhiều mà delist thì ít, nên khả năng Binance đổi chiến lược list coin để ăn phí giao dịch nhiều hơn đẩy giá $BNB. Không phủ nhận Binance vẫn là sàn giao dịch có volume top1 hiện nay, và coin nào được list thì vẫn sẽ có tiềm năng tăng trưởng cao. Tuy nhiên trong thời gian tới, khả năng Coin Binance sẽ dần bão hòa khi thị trường ngày càng có nhiều sự lựa chọn. Xét về chiêm tinh: Bản đồ này đang chạy vận sao Hỏa, đây là vận tương đối không tốt cho giao dịch. Có thể thấy từ năm 2022, khi bắt đầu vận Hỏa thì Binance mới bắt đầu vướng vào các vấn đề pháp lý trầm trọng. Trong 2 chu kỳ tiếp theo là chu kỳ Hỏa - Thổ tháng 6/2024 và chu kỳ Hỏa - Thủy tháng 7/2025 đều không thuận lợi. Hỏa sẽ phá hoại một điều gì đó - ở đây vị trí của nhà 10 thuộc Song Tử thì khả năng là về danh tiếng và thành quả trước đây. Thổ sẽ đình trệ một điều gì đó - Thổ nhà 3 sẽ gây ra những thỏa hiệp bất thành. Trong Transit hiện tại, sao Thổ đang chiếm đóng nhà thứ 6 là ngôi nhà chủ về nợ nần => tạo ra những khoản nợ khó trả. Có thể thấy từ sau khi sao Thổ di chuyển vào ngôi nhà này thì Binance dính khoản phạt 4 tỷ đô. Tuy nhiên điều này không có nghĩa là Binance sẽ sập, hoặc BNB không tăng giá nữa, điều này cho thấy rằng khi Binance bị vùi dập, thì khả năng cao sẽ có một thế lực khác trỗi dậy. Tôi out 50% $BNB đơn giản là vì lợi nhuận đủ rồi, và thêm nữa là tôi sẽ quan sát cơ hội ở những dự án tiềm năng khác để invest lợi nhuận vào.





Vài dự đoán Chiêm tinh Vedic cho năm 2025 Ngày 29/3/2025 Sao Thổ sẽ di chuyển vào cung cuối cùng của vòng hoàng đạo đó là Song Ngư, nó sẽ ở đây đến tháng 9/2027 Song Ngư là dấu hiệu của sự tự do, mở rộng, vị tha.=> nhiều quốc gia sẽ thoát khỏi chiến tranh xung đột. Vì thế, các vấn đề xung đột, nổ súng, bắn tên lửa sẽ giảm dần nên mọi người khoan lo ww3, ít nhất là từ giờ đến 2027. Thổ đi vào Song Ngư mở ra thời kỳ nữ quyền, nhiều nữ lãnh đạo sẽ vươn lên và tỏa sáng trong chính trị, kinh tế, thể thao, viết lách, nghệ thuật. Chúng ta thấy kỷ nguyên nữ quyền đã dần dần chiếm đóng ở mọi lĩnh vực của xã hội, và sắp tới sẽ là những vị trí quan trọng trong chính trị. Song Ngư là cung mộng mơ, ảo ảnh, vì vậy 2025 sẽ là lúc bùng nổ về trend NFT, crypto, thiết kế đồ họa. Khớp với chu kỳ tăng trưởng của Crypto hậu #BitcoinHalving Song Ngư nói lên sự thuần khiết, linh thiêng, => Con người sẽ nói nhiều về sức khỏe tinh thần, hướng về cuộc sống đơn giản, lĩnh vực tâm linh sẽ phát triển. Ngành, nghề tâm linh đang dần đi vào đời sống và kiếm ra lợi nhuận lớn. Lưu ý: là chiêm tinh Vedic sử dụng dữ liệu thiên văn, vì vậy sẽ khác những bộ môn chiêm tinh khác